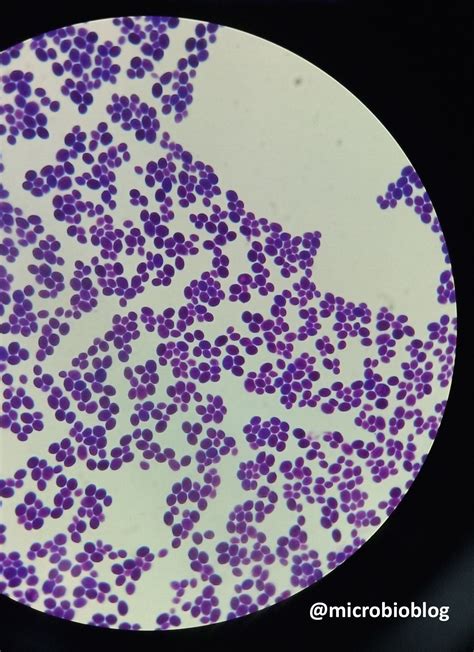

Il lievito madre, spesso chiamato semplicemente "madre", è diventato un ingrediente fondamentale nella panificazione, sia per prodotti dolci che salati. Tuttavia, è essenziale comprendere se il suo utilizzo sia sempre giustificato e corretto. Questo articolo esplora in dettaglio il lievito madre, i suoi componenti, la biodiversità microbica e il ruolo degli starter nella panificazione.
S.cerevisiae al microscopio DIC (Wikipedia)
Il Protagonista: Il Lievito Madre
Il lievito madre, noto anche come "lievito naturale" o "impasto acido", è un elemento chiave nella panificazione. La sua popolarità è cresciuta a tal punto da sembrare una panacea per tutti i problemi legati alla lievitazione. Molti fornai ne dichiarano l'uso per nobilitare i loro prodotti, a volte trascurando altre caratteristiche importanti. È fondamentale valutare se il lievito madre sia effettivamente così straordinario e se venga impiegato nel modo corretto.
Saccharomyces cerevisiae: La Guest Star
Il Saccharomyces cerevisiae è un lievito utilizzato da secoli nella fermentazione di vino, birra e pane. Le sue cellule, con un diametro di 5-10 micrometri, si moltiplicano tramite gemmazione, producendo individui identici al precedente. Questo lievito è allevato industrialmente e commercializzato in cubetti o in forma liofilizzata. Sebbene resistente, il Saccharomyces cerevisiae ha un range ambientale ottimale, con temperature ideali tra i 18-24 gradi e un pH neutro-basico.
La Biodiversità nel Lievito Madre
Per approfondire i meccanismi del lievito madre, sono stati consultati Nicola Francesca, Giancarlo Moschetti e Luca Settanni, docenti e ricercatori di microbiologia presso l'Università di Palermo. Le loro ricerche hanno dimostrato che la biodiversità attribuita al lievito madre è reale e contribuisce a caratterizzare l'impasto con numerose componenti volatili aromatiche. Anche nel lievito di birra commerciale è presente una certa biodiversità, ma limitata ai diversi ceppi di Saccharomyces cerevisiae e ad alcuni batteri lattici. Durante la lievitazione, le azioni dei batteri sono spesso più importanti di quelle dei lieviti, con un rapporto ottimale di 100:1 tra batteri e lieviti in un lievito madre sano.

Alveolatura presso Pizzeria Kalinikta (2015)
Contaminazioni e Miti da Sfatare
La contaminazione del lievito madre è un processo continuo, coinvolgendo una varietà di lieviti e batteri presenti nell'ambiente. Tuttavia, è un mito infondato l'uso di alimenti specifici come lo sterco di cavallo o il succo d'uva per caratterizzare il lievito madre. Questi ingredienti introducono contaminazioni deleterie o zuccheri che alterano l'equilibrio microbico dell'impasto acido. È preferibile utilizzare solo acqua e farina per la generazione e il rinfresco del lievito madre, evitando l'aggiunta di zuccheri che potrebbero favorire alcune popolazioni microbiche a discapito di altre.
L'Importanza del pH
Giuseppe Russo, biologo e nutrizionista, spiega che un lievito sano ha un pH di circa 3,8 - 4,4, che impedisce la sopravvivenza dei microorganismi presenti nel lievito di birra. Tuttavia, un lievito madre non in perfetta salute, con un pH superiore a 4,5, è più suscettibile alla contaminazione da Saccharomyces cerevisiae, trasformando l'impasto acido in una coltura di lievito di birra. Questo potrebbe spiegare le scarse differenze organolettiche tra le pizze lievitate con lievito madre e quelle con lievito di birra, spesso dovute all'uso di uno "starter" di lievito di birra per compensare un lievito naturale non sano.

Un'alveolatura del panettone di Pino Lo Faso (2014)
Lievito Madre vs. Lievito di Birra: Un Confronto
Stefano Pibi, esperto di panificazione, sottolinea che si possono ottenere ottimi prodotti sia con il lievito madre che con il lievito di birra, a patto di utilizzarli correttamente. Il lievito di birra commerciale è una concentrazione di Saccharomyces cerevisiae, mentre il lievito madre nasce dalla contaminazione spontanea di acqua e farina da parte di batteri e lieviti selvaggi. In un lievito madre equilibrato, i lattobacilli superano di gran lunga i Saccharomyces, innescando processi complessi che dipendono da vari fattori come l'idratazione, la temperatura e il tipo di farina.
Considerazioni per l'Uso Professionale
L'adozione del lievito madre nelle pizzerie richiede una valutazione attenta. Per chi deve produrre grandi quantità di pizza, il rischio di fallimento è un fattore determinante. In questi casi, molti optano per una lievitazione mista, utilizzando una piccola percentuale di lievito di birra (0,1% - 1%) insieme al lievito madre. Questo metodo, noto come "starter", suscita un dibattito tra chi crede che il lievito di birra ceda il passo al lievito madre e chi sostiene che il Saccharomyces domini comunque la lievitazione.
Alternative e Tecniche di Lievitazione
Esistono diverse alternative per chi desidera utilizzare il lievito madre senza correre rischi eccessivi. Alcune pizzerie affiancano alle pizze con lievito di birra quelle con lievito madre, minimizzando i rischi e offrendo una scelta più ampia ai clienti. L'adozione della tecnica del freddo aiuta a prevenire la sovralievitazione e l'acidificazione della pasta, tecniche utilizzate anche con il lievito di birra per gestire grandi quantità di impasto.
LIEVITO MADRE PASTA MADRE come fare il lievito naturale lievito madre pasta madre in pochi giorni
Conclusioni
In conclusione, si possono ottenere pizze eccellenti sia con il lievito di birra che con il lievito madre, a condizione di fare scelte informate e di utilizzare le tecniche appropriate. È fondamentale promuovere una cultura della panificazione che valorizzi la qualità degli ingredienti e la professionalità dei panificatori, senza demonizzare a priori nessuna tecnica di lievitazione. Un cliente soddisfatto e ben informato saprà riconoscere una pizza fatta male, indipendentemente dal tipo di lievito utilizzato.
Tabella Comparativa: Lievito Madre vs. Lievito di Birra
| Caratteristica | Lievito Madre | Lievito di Birra |
|---|---|---|
| Composizione | Biodiversità di lieviti e batteri | Saccharomyces cerevisiae (ceppi selezionati) |
| Preparazione | Contaminazione spontanea di acqua e farina | Allevato industrialmente |
| pH ottimale | 3,8 - 4,4 | Neutro-basico (superiore a 7) |
| Uso | Panificazione artigianale, prodotti a lunga lievitazione | Panificazione industriale, prodotti a lievitazione rapida |

Pizza napoletana cotta nel forno a legna